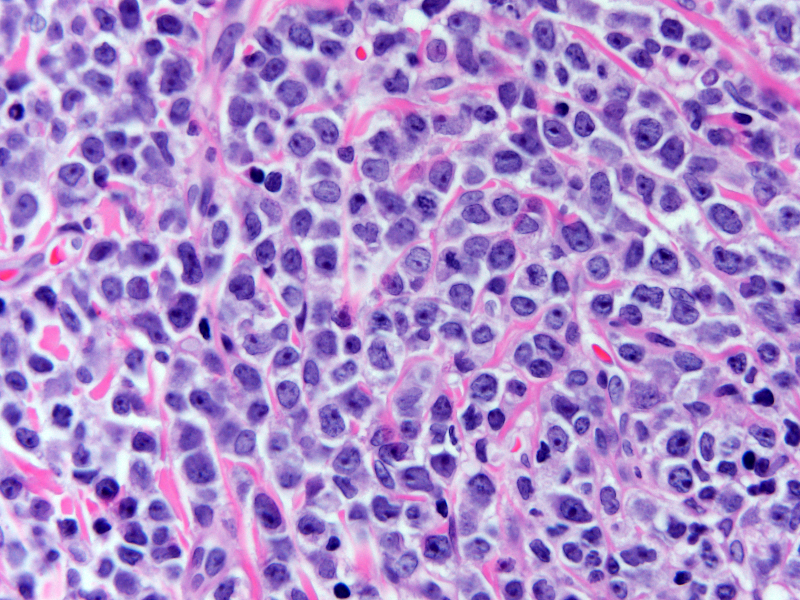
Skin of left upper thigh mass (H&E, 600X) shows a monotonous population of large mononuclear cells with fine chromatin and visible nucleoli.

Institution: Memorial Medical Center, Springfield, Illinois
Session: Extramedullary manifestations of myeloid neoplasms
HISTORY
23 year old previously healthy male presents with a two month history of a mass on left inner thigh and parietal scalp which was gradually increasing in size. Complete blood count was normal (Hemoglobin 14.1 g/dL, leukocyte count 7.6K, and platelet count 245K).
DETAILS
Excisional biopsy of the left inner thigh mass was performed. Gross inspection of the lesion revealed a surface greenish tan plaque which extended into the dermis and subcutis. Touch preparations showed a monomorphic population of large mononuclear cells with fine chromatin and scant basophilic cytoplasm. Histologic sections were fixed in either 10% buffered formalin or acetic zinc formalin. Initial touch preparation of the mass revealed a population of blasts with fine chromatin and scant basophilic cytoplasm. Histologic evaluation revealed a dense proliferation of large mononuclear cells with fine chromatin diffusely involving the dermis and subcutis. The infiltrate focally extended into the epidermis.
IMMUNOHISTOCHEMISTRY AND FLOW CYTOMETRY
Three color flow cytometric analysis of the left inner thigh mass revealed an abnormal population of myeloid blasts. The myeloid blasts were positive for CD13, CD33, CD34, CD117, myeloperoxidase, HLA-DR, CD15 (partial expression), and CD7 (aberrant expression) and were negative for CD14, CD64, TdT, CD16, and CD56. Limited immunohistochemical stains on the left inner thigh mass showed that the neoplastic cells were positive for CD43, CD34, and CD117.
CYTOGENETIC FINDINGS
Cytogenetic analysis was performed on the left inner thigh mass by ARUP Laboratories and revealed a normal karyotype, 46, XY in twelve metaphase cells. The analysis was suboptimal as metaphase cells could only be obtained from the monolayer cultures. Suspension cultures failed to yield any metaphase cells. The findings raised the possibility that the karyotype may be constitutional rather than from the malignant cells.
Fluorescent in situ hybridization studies showed no evidence of monosomy 7, t(8;21), t(9;22) or rearrangements involving the MLL or CBFB loci in 200 cells scored.MOLECULAR FINDINGS
Molecular analysis was not performed.
INTERESTING FEATURES
During the course of the disease, the patient never developed acute leukemia in the peripheral blood or bone marrow. This is despite initial occurrence and relapse in various extramedullary sites including skin, cerebrospinal fluid, ear, perineum, and lymph node. Despite allogeneic stem cell transplant, the patient developed graft-versus-host-disease and died approximately six years after initial diagnosis.
PROPOSED DIAGNOSIS
Myeloid sarcoma
CONSENSUS DIAGNOSIS
Myeloid sarcoma (granulocytic diffentiation; thigh and scalp masses)
| Touch preparation of left inner thigh mass reveals an abnormal population of blasts with fine chromatin and scant basophilic cytoplasm |  |
| Skin of left upper inner thigh (H&E, 200X) shows a dense infiltrate involving the dermis and subcutis |  |
| Skin of left upper thigh mass (H&E, 600X) shows a monotonous population of large mononuclear cells with fine chromatin and visible nucleoli. | |
| Skin of left upper inner thigh (CD117, 1000X) shows diffuse strong positivity |  |
| Flow cytometric analysis shows that the CD45 dim cells with moderate side-scatter (blasts) are positive for CD34, CD117, CD15 (partial expression), and myeloperoxidase |  |
| Flow cytometric analysis also shows that the cells are positive for CD13, CD33, and CD7 (aberrant expression) and are negative for CD14, CD64,CD10, and TdT |  |